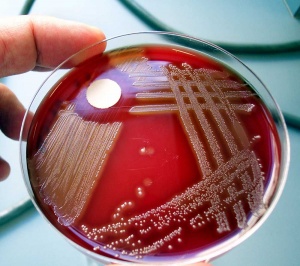

La bacteria que ocasionó la infección generalizada que desencadenó este sábado la muerte de Luana es la streptococcus pyogenes, la misma que provocó la muerte de dos niños en el hospital Elizalde de Buenos Aires y una nena en Rosario, por la que la Secretaría de Salud de la Nación dio alerta epidemiológica.
La bacteria que ocasionó la infección generalizada que desencadenó este sábado la muerte de Luana es la streptococcus pyogenes, la misma que provocó la muerte de dos niños en el hospital Elizalde de Buenos Aires y una nena en Rosario, por la que la Secretaría de Salud de la Nación dio alerta epidemiológica.
Así lo confirmaron ayer el ministro de Salud Pública, Walter Villalba, y los mismos padres de Luana, de siete años, que habían recibido los resultados de los cultivos realizados en el Sanatario Caminos donde la pequeña fue internada el viernes y falleció al día siguiente.
En tanto, el director de Emergencia de la provincia, Orlando Querencio, habló con PRIMERA EDICION de un segundo caso de infección generalizada por streptococccus pyogenes en una joven de 27 años que se había pinchado con una espina y en pocas horas derivó en una sepsia. No obstante, después de tres semanas de internación, la joven logró superar el cuadro y fue dada de alta.
Bacteria frecuente que rara vez es mortal
El alerta epidemiológico y la muerte de cuatro chicos (dos en Buenos Aires, uno en Rosario y otro en Posadas) por causa de esta bacteria en menos de una semana desencadenó ayer mucho miedo en la sociedad.
Los infectólogos fueron consultados ayer por todos los medios de comunicación y todos, sin excepción, explicaron que se trata de una bacteria muy frecuente que generalmente se aloja en vías respiratorias y piel, causante de la mayoría de las anginas y de infecciones como la escarlatina.
Pero también puede ser muy peligrosa si se dispersa en la sangre y ocasiona una infección que llega a todo el organismo. Esto último puede ocurrir cuando hay otra enfermedad, que debilita el sistema inmunológico, asociada a la bacteria.
Según explicó a PRIMERA EDICIÓN la médica infectóloga Liliana Arce, jefa del área en el hospital de Pediatría, “la bacteria streptococcus pyogenes produce la famosa faringitis con placas, escarlatina, infecciones en la piel e incluso meningitis. Es una bacteria muy común que a veces produce una toxina que desencadena una infección invasiva, es decir que afecta a todo el cuerpo. Lo vemos frecuentemente asociada con la varicela, primero provoca una celulitis o infección en las partes blandas y luego una infección generalizada. También puede provocar miositis, que es la inflación del músculo, y eso genera mucho dolor. Hay que estar muy atentos ante estos cuadros, hay que hacer análisis de laboratorio, ecografías y resonancias porque es rápidamente progresivo pues las toxinas producen un cuadro sistémico de sepsis que es cuando la bacteria pasa a la sangre y empieza a agotar todos los factores de coagulación por lo que el paciente empieza a sangrar (mucosa, encía, hematomas en la piel); esta es la fase avanzada de la enfermedad que termina con un shock séptico”.
Prevención y tratamiento
No hay vacunas que eviten contraer streotococcus pyogenes. La penicilina es el tratamiento contra esta bacteria cuando está focalizada, “pero cuando es invasiva, o sea que no solamente está en la garganta sino en todo el cuerpo, se suma a la penicilina otro antibiótico para las toxinas”.
Al ser consultada sobre qué determina que esta bacteria pase a la sangre y se convierta en invasiva, la especialista señaló que
hay factores predisponentes como pueden ser un golpe previo o la entrada anterior de un virus que actúa como un paralizador del sistema inmunológico, facilitando la introducción del estreptococco”.
De fácil contagio
Según confirmó Arce, la bacteria es de fácil contagio, “está en las fauces por lo que se contagia a través de la tos, secreciones de saliva; puede estar en granitos y también se contagia a través de contactos con la piel”.
No obstante, la especialista trató de dar tranquilidad a los padres y en particular a los compañeros de la niña fallecida (que era alumna del Instituto Estrada) “siempre la muerte de un niño sensibiliza a todos, a los padres, a la escuela, a los amigos… no solo por la pérdida sino también por el temor a contraer la enfermedad. Por eso es importante saber que este streptococcus pyogenes es contagioso, si la nena lo tenía en la garganta y tuvo contacto más de cinco horas con otros chicos pudo haber transmitido la bacteria. Por ello, hay que alertar a los padres que si sus hijos presentar fiebre avisen que fueron compañeritos de Luana para los médicos sepan que hubo contacto y estén atentos. Es probable que solo tengan una faringitis y no una enfermedad invasiva. No hay enfermedad, hay enfermos… cada organismo actúa de forma diferente con la bacteria dependiendo de su sistema inmunológico”, recordó la profesional.
Situación de alerta
Recomendó a todos los padres la consulta médica temprana ante cuadros respiratorios y de fiebre y a los médicos que no se queden con el diagnóstico clínico. Aconsejó, incluso, “que el chico quede internado en observación durante 24 a 48 horas para hacerle los estudios que, a veces, es muy difícil hacer rápidamente en forma ambulatoria. Además, al estar internado, hay posibilidades de controlarlos de cerca y que los médicos tengan su propio relato de lo que le pasa al chico”, indicó.
Destacó además que hay muchas virosis y ello genera una super población en las guardias pediátricas, “pero los médicos tienen la formación y herramientas para determinar cuáles son falsas alarmas; sé que es difícil atender a un paciente y tener otros 40 ó 50 esperando en la guardia, pero es muy importante poner las pautas, explicar a la familia cuáles son los indicadores que deben motivar su regreso inmediato a la consulta”.
Recordó que los profesionales de salud cuentan con un abanico de estudios para distinguir un cuadro bacteriano invasivo, “desde una inmunofluorescencia directa, un hisopado naso faringe, un hemograma para ver cómo están los glóbulos blancos, un urocultivo para descartar una infección urinaria, un hemocultivo, una radiografía o el estudio que el médico considere más adecuado en función del cuadro del paciente”.
Más cuadros gripales
En el hospital de Pediatría permanece internado un paciente con gripe B y en las últimas horas fueron dados de alta dos pacientes con gripe A. Pero en los consultorios creció la demanda de atención por estos cuadros en la última semana.
“La influenza es un virus de la primavera, no sólo del invierno. Lo que hubo este año es un corrimiento epidemiológico, lo que antes se presentaba en junio y julio, este año lo vimos a fines de agosto y en septiembre”, detalló la jefa de infectología de ese nosocomio, Liliana Arce.
En este contexto, señaló que las escuelas y sobre todo los niveles iniciales, son lugares donde se da una mayor transmisión porque es muy difícil que los niños hagan un barrido de la tos o no compartan utensilios.
Muerte por gripe A
Hace una semana falleció en Posadas Abigail, una beba de un año y dos meses, como consecuencia de un cuadro de Gripe A y neumonía. Antes de entrar al hospital de Pediatría la atendieron tres pediatras en el sector privado, sin dar con el diagnóstico adecuado.
“Yo atendí a la beba una vez que fue ingresada en terapia del hospital, no antes”, precisó la médica infectóloga Liliana Arce.
“Acá se está hablando y tienen razón, sobre las múltiples consultas que se hicieron antes de que se llegue al diagnóstico.Las guardias están superpobladas, con eso no justifico que no se revise bien a los chicos… pero a veces es muy difícil cuando hay 40 ó 50 chicos esperando afuera. Pero cuando un niño ya viene en múltiples ocasiones algo tiene que tener, lo idea en esos casos es que se piense un poco más allá y vea si a ese niño le hace falta algo más que un examen físico”, advirtió.







